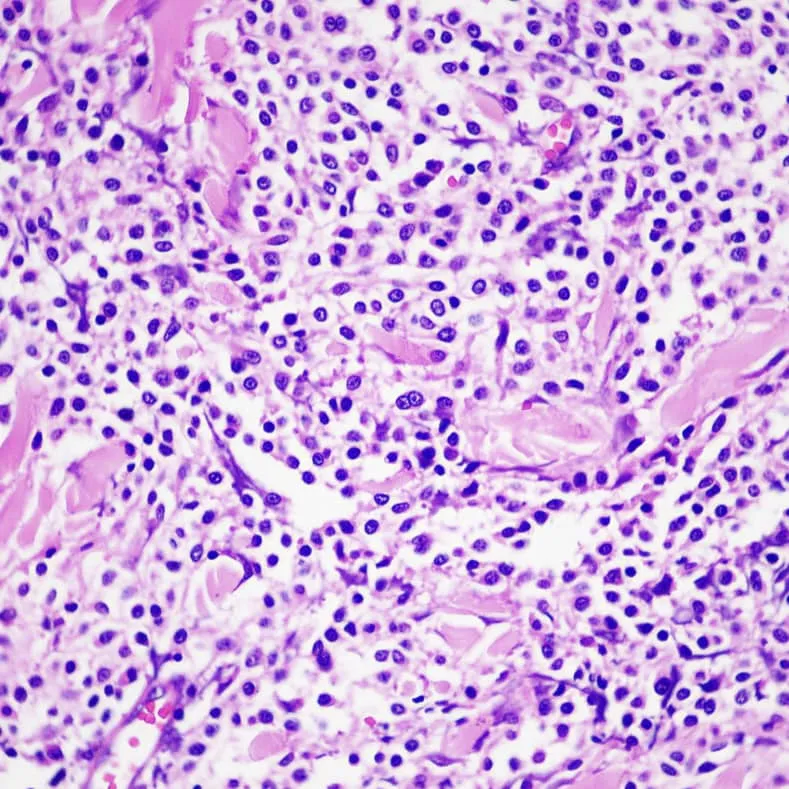

貓咪眼瞼肥大細胞瘤切除

「眼睛下面長了腫瘤,可以切除嗎?」
🐱貓咪眼瞼肥大細胞瘤切除👁️
⚠️貓與狗的肥大細胞瘤(Mast cell tumor)治療方式大不同、此為貓之病例⚠️
長在眼睛周圍的腫塊可以說是千奇百怪,有些只是發炎,有些卻是惡性腫瘤,放著不管可能導致視力的喪失,或者擴散全身無法治療!
因此不論是長在身體的那個部位,來安可檢查醫師一定是建議先採樣確診!再根據檢查的結果給出適當的治療。
有些家長會問,醫師為何不直接手術切除?
🐾
這時候我們都會舉個簡單的例子:比如長在腳趾的一個腫塊,經過採樣可能有三個可能🤔️:
1. 舔舐性肉芽腫:吃藥就可以消退,不必開刀。
2. 皮脂腺瘤:只要做一個小手術切除就好,癒合之後好像沒做過手術。
3. 黑色素瘤或鱗狀上皮細胞癌:要想不擴散或復發,很高機率要截趾、甚至截肢!
所以要醫師直接開刀,在沒有確定病因之前,真的很難做出正確的選擇,貿然治療,過猶不及,往往留下遺憾。
就像今天分享的病例,左眼下眼瞼區域的皮膚團塊就是一個很好的例子,正是因為先有確切的診斷,才能幫助醫師做出正確的治療,在清除腫瘤的同時,保留眼瞼的功能!
1. 經過採樣診斷:確認為肥大細胞瘤。
2. 在貓貓的肥大細胞瘤,有部分病例會自行消退,但由於經過一段時間觀察,腫瘤越長越大,若腫瘤過大才切除擔心後續影響視力因此安排切除。
3. 貓咪的肥大細胞瘤與狗狗不同,邊緣切除就可以達到很低的復發機率,因此採取邊緣切除以保留最多眼周組織!
👁️💉
手術採取邊緣切除移除腫瘤,保留最重要的眼瞼邊緣、角結膜交接處與腺體,大大的降低術後造成角膜刺激與嚴重變形的機會。
採用前移皮瓣手術修補缺損,使眼周張力儘量維持術前水準,避免術後無法閉眼,造成乾眼性角膜傷害。
手術每個環節對於視力的保持都很重要,然而這些規劃,若用在邊緣切除復發極高的鱗狀上皮細胞癌,可能還沒拆線就復發了!
先採樣確診在治療,一直都是腫瘤治療最重要的一環!醫師在這邊呼籲身上有不明腫塊的狗狗貓貓,都要接受採樣檢查,對於後續的醫療才是最有利的喔!
🐱貓咪眼瞼肥大細胞瘤切除👁️
⚠️貓與狗的肥大細胞瘤(Mast cell tumor)治療方式大不同、此為貓之病例⚠️
長在眼睛周圍的腫塊可以說是千奇百怪,有些只是發炎,有些卻是惡性腫瘤,放著不管可能導致視力的喪失,或者擴散全身無法治療!
因此不論是長在身體的那個部位,來安可檢查醫師一定是建議先採樣確診!再根據檢查的結果給出適當的治療。
有些家長會問,醫師為何不直接手術切除?
🐾
這時候我們都會舉個簡單的例子:比如長在腳趾的一個腫塊,經過採樣可能有三個可能🤔️:
1. 舔舐性肉芽腫:吃藥就可以消退,不必開刀。
2. 皮脂腺瘤:只要做一個小手術切除就好,癒合之後好像沒做過手術。
3. 黑色素瘤或鱗狀上皮細胞癌:要想不擴散或復發,很高機率要截趾、甚至截肢!
所以要醫師直接開刀,在沒有確定病因之前,真的很難做出正確的選擇,貿然治療,過猶不及,往往留下遺憾。
就像今天分享的病例,左眼下眼瞼區域的皮膚團塊就是一個很好的例子,正是因為先有確切的診斷,才能幫助醫師做出正確的治療,在清除腫瘤的同時,保留眼瞼的功能!
1. 經過採樣診斷:確認為肥大細胞瘤。
2. 在貓貓的肥大細胞瘤,有部分病例會自行消退,但由於經過一段時間觀察,腫瘤越長越大,若腫瘤過大才切除擔心後續影響視力因此安排切除。
3. 貓咪的肥大細胞瘤與狗狗不同,邊緣切除就可以達到很低的復發機率,因此採取邊緣切除以保留最多眼周組織!
👁️💉
手術採取邊緣切除移除腫瘤,保留最重要的眼瞼邊緣、角結膜交接處與腺體,大大的降低術後造成角膜刺激與嚴重變形的機會。
採用前移皮瓣手術修補缺損,使眼周張力儘量維持術前水準,避免術後無法閉眼,造成乾眼性角膜傷害。
手術每個環節對於視力的保持都很重要,然而這些規劃,若用在邊緣切除復發極高的鱗狀上皮細胞癌,可能還沒拆線就復發了!
先採樣確診在治療,一直都是腫瘤治療最重要的一環!醫師在這邊呼籲身上有不明腫塊的狗狗貓貓,都要接受採樣檢查,對於後續的醫療才是最有利的喔!